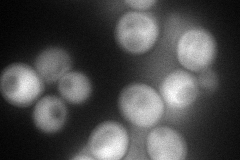
YGL241W
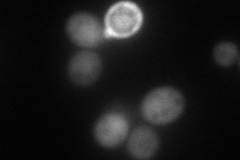
YGL241W
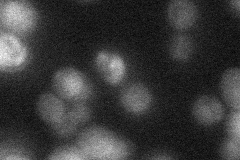
YGL241W
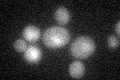
YGL241W

View description
Karyopherin, responsible for nuclear import of Spt15p, histones H2A and H2B, and Nap1p; amino terminus shows similarity to those of other importins, particularly Cse1p; localization is primarily nuclear
Localization:
Intensity:
Fold change:
Significance:
-
C’ GFP library in SD

nucleus:cytosol27.27 -
N' NOP1pr-GFP in SD
cytosol99.3661 -
N' TEF2pr-mCherry in SD
cytosol107.316 -
N' NATIVEpr-GFP in SD
nucleus25.2562 -
N' TEF2pr-VC and Cyto-VN in SD

cytosol45.8574 -
C’ GFP library in SD+DTT

nucleus.cytosol26.440.96No -
C’ GFP library in SD+H2O2

nucleus.cytosol29.31.07No -
C’ GFP library in Starvation Media
nucleus,cytosol23.770.87No -
C’ GFP library on the background of Pup2-DaMP

nucleus:cytosol -
C’ GFP library on the background of CCT mutant

nucleus:cytosol29.76111.09101No
